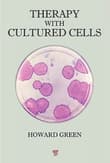
Book cover of Therapy with Cultured Cells

Howard Green's most recommended books
We've asked 12,000+ authors and super readers for their favorite books. Here are their favorite books by Howard Green.
Book lists with Howard Green's books
1 authors created a book list with a book by Howard Green as one of their picks.
Book lists connected to Howard Green's books
141 authors created a book list connected to Howard Green's books by genre, topic, theme, and mood.
Genres connected to Howard Green's books
Science
2758 books